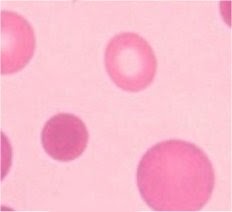

Spherocytosis - An Overview
Created 7 October 2010.
Updated 1 August 2021 (added new case study)
Updated 7 January 2026 (updated to new format)
Here’s a real-life full blood count result;
just one among dozens that I happened across as I do.
|
HBM WBCM PLT HCT RBCM
MCVM MCHM MCHCM RDW N 310517 118
10.60 243 0.364 4.08 89.2 28.9
324 16.5 7.60 170817 125
14.80 309 0.387 4.37 88.6 28.6
323 17.5 9.30 031017 118
11.50 266 0.358 4.10 87.3 28.8
330 16.6 7.20 121218 F 125
18.08 342 0.367 4.27 85.9 29.3
341 16.3 12.09 L
M E B RET%
RETA IRF NUC GF
ESR 310517 2.20 0.60
0.10 0.00 5.3 214.00
7.4 170817 4.20 0.90
0.30
0.10 031017 3.10 0.90
0.30 0.10 8.2 336.00 12.2
11 121218 F 4.44 1.12
0.33 0.10 7.2 309.10 14.1
11 |

The blood count was normal in all respects.. but
for the reticulocyte count. Lots of young red cells. Clearly in increase in red
cell production. But a normal haemoglobin. What’s going on there? A
well-compensated haemolytic process was taking place.
And then I looked down the
microscope
The average red cell has a biconcave
disc shape – you can tell this from the central pallor of the cell. Spherocytes
lack this pallor – indeed the colour is darker towards the centre as these
cells are thickest there.
Biconcave cells are flexible. Rather
akin to a floppy bag of water. A spherocyte is spherical and is not so
flexible. Rather akin to a balloon.
Hereditary
Spherocytosis arises from a malformation in the red cell membrane caused by ah
hereditary defect in one (or more) of the constituents of the
erythrocytic cytoskeleton. Proteins most commonly at fault are
·
Spectrin
·
Ankyrin
·
Band 3
·
Protein 4.2.
Because the cell
skeleton is defective the red cell contracts to a sphere through surface
tension. Though the spherocytes have a smaller surface area through which
oxygen and carbon dioxide can be exchanged compared to “normal” red
cells, they perform adequately. However due to the relative inflexibility of
the cells they have a shortened lifespan.
Hereditary spherocytosis has a
range of presentations depending on the severity of the red cell problem
ranging from a well-compensated condition which is little more than a
microscopic curiosity through to full-blown ongoing anaemia.
It is also claimed
by some sources that the Rh null phenomenon gives rise to spherocytosis (it
says so on Wikipedia so it must be true!). Presumably the missing Rh
antigens are in part responsible for the red cells shape.
Acquired
Spherocytosis occurs when there has been loss of membrane from otherwise normal cells
and the cells have therefore contracted to a spherical shape. This loss can be
immune-mediated or actual physical loss, and is seen in:
·
Autoimmune hemolytic anemia
·
Paroxysmal cold hemoglobinuria
·
Acute and delayed haemolytic transfusion reactions
·
Haemolytic diseases of the newborn (HDN)
·
hypophosphatemia
·
Bartonellosis
·
Snake bite
·
hypersplenism
·
Burns
·
D.I.C
Testing for Spherocytosis is generally
confirmatory. After all, seeing spherocytes is somewhat definitive, isn’t it?
Confirmatory
testing in cases of acquired spherocytosis generally isn’t performed. After all
the spherocytosis will be resolved when the cause of the spherocytosis is
resolved.
The supposedly Gold
Standard test for hereditary spherocytosis (the osmotic fragility test)
was once commonplace in the district general hospital. However the demands of
ISO standards and the fact that up to twenty percent of cases with marked
spherocytes have a normal osmotic fragility has lead
to the rise of the use of flow cytometry for such determinations.
A Case Study
A patient reported
for ante-natal clinic at which a blood count was performed. She proved to be a
tad anaemic, and the analyser suspected nucleated red cells (which isn’t an
uncommon thing for it to suspect in pregnancy). For these reasons a blood
film was made, and spherocytes were seen.
|
OTHERWISE, WELL DOB
29/09/1977 Sex F Pat No 666999
Source ANC Received
12:58 Address
SOMEWHERE
IN EUROPE,
Clinician
WHO
07/10/2010 Specimen No :
AW203214B (Haematology)
07/10/2010
11:15 EDTA Haemoglobin
10.7
g/dl ( 11.0 to
15.0 ) Auth White
Blood Cells
10.5
10^9/l ( 4 to
11 ) Auth Platelets
414
10^9/l ( 150 to 400
) Auth Red Blood
Cells
3.55
10^12/l ( 3.8 to 4.8 )
Auth
Haematocrit
0.320
ratio ( 0.36 to 0.46 )
Auth Mean Cell
Volume
91.3 fl
( 80 to 100 ) Auth Mean Cell
Haemoglobin
30.1 pg
( 27 to 32 ) Auth Mean Cell
Haemoglobin Con
33.0
g/dl ( 32
to 36 ) Auth Neutrophils
7.7
10^9/l ( 2 to 7.5
) Auth
Lymphocytes
2.0
10^9/l ( 1.5 to 4
) Auth
Monocytes
0.6
10^9/l ( 0.2 to 1
) Auth
Eosinophils
0.2
10^9/l ( 0.02 to 0.5 )
Auth
Basophils
0.0
10^9/l ( 0 to
0.1 ) Auth XE
FLAG1
Spherocytosis
++
Auth XE
FLAG2
^A blood film has been
reviewed
Auth
Cursor
Down for more |
The patient’s (real)
name rang a bell – I knew this patient had hereditary spherocytosis. This is a
condition in which the patient’s red cell survival is decreased because of a
problem with red cell membrane structure. Rather than being biconcave discs,
the patient’s cells are spherical. Therefore not so
flexible, and don’t live as long. Normally this condition is well compensated,
but when the patient is unwell for other reasons, the HS can be aggravated and
cause an anaemia.
Usually spherocytes are
detected microscopically. In the case above a blood film was made because blood
count parameters fell outside the reference range, and the automated analyser
suspected nucleated red cells (which isn’t uncommon in pregnancy).
However I’m left
wondering. Someone with HS having a blood count for any other reason may well
have normal numerical results (it happens!), and with no blood film
being made, the condition would go unnoticed. In fact
the patient under consideration has had six previous blood counts over the last
three years, none of which triggered the making of a blood film by the
automation.
So we have a
potential failing in the system. We are (potentially) not finding cases
of hereditary spherocytosis. At first thought I was rather concerned, but then
again, does this actually matter? Many cases of HS
(and the related HE) are often not clinically significant. Some patients with
these conditions can (and do) go their entire lives with absolutely no problems
being generated by the well-compensated haemolytic process.
It was suggested
that cases of HS have raised reticulocytes and so we could use that as a
pointer, but performing reticulocyte counts on every blood count would get
rather expensive and would slow the process down. In conversation with colleagues it was suggested that the spherocytic cells may
well scatter light differently to biconcave discs, and that maybe one of the XE
channels might find spherocytes. I relayed this suggestion to the analyser’s
manufacturer who said not, but they were rather flummoxed by this problem.
After some discussion we came to the conclusion that a
case of HS which actually needs to be diagnosed will
present either clinically with jaundice and/or anaemia, or
will have an obvious problem with the blood count. And in 99.9% of the time
will be suspected from a family history.
So there’s no need to
change practice (at the moment…)
And here’s another
one
|
|
P1234567
KIRK James T
03.07.08 M
Specimen R,21.3133950.J
Clin dets Lower respiratory tract infection. . Collected 27.07.21 11:56
A.Diag PT
+ 16.2 |Lymphs
1.28 APTT
31.7 |Monos
+ 2.32 FIB
+ 5.31 |Eosin
0.02 Hb
- 118 |Baso + 0.13 WBC
+ 30.82 |MPV
10.0 Plts
402 |PCT
0.40 Hct
- 0.325 |NRBC
0.02 RBC
- 3.77 | MCV
86.2 | MCH
31.3 | MCHC + 363
| Neuts + 27.07
| |
“Lower
respiratory tract infection”… well – that explains the neutropenia but look
at the anisopoikilocytosis and anisochromia…
and spherocytes (!!!)
It turns out that
James T Kirk (not the real name!) had been diagnosed with hereditary
spherocytosis when a baby, and has had two or three
blood count for various reasons in the meantime. Each time kicking off the sort
of excitement that I felt when thinking I’d uncovered a new case of hereditary
spherocytosis…
Some More Expert Opinion…:
https://docs.google.com/document/d/1_78tWsypqD1ehDQiXn2c90IbIgF1eOfkFbGtNvj9aiE/edit?usp=sharing
https://en.wikipedia.org/wiki/Spherocytosis
https://www.sciencedirect.com/topics/medicine-and-dentistry/spherocytosis
https://www.ncbi.nlm.nih.gov/pubmed/27837594
http://adulldayatwork.blogspot.com/2010/10/october-7-2010-thursday-hereditary.html